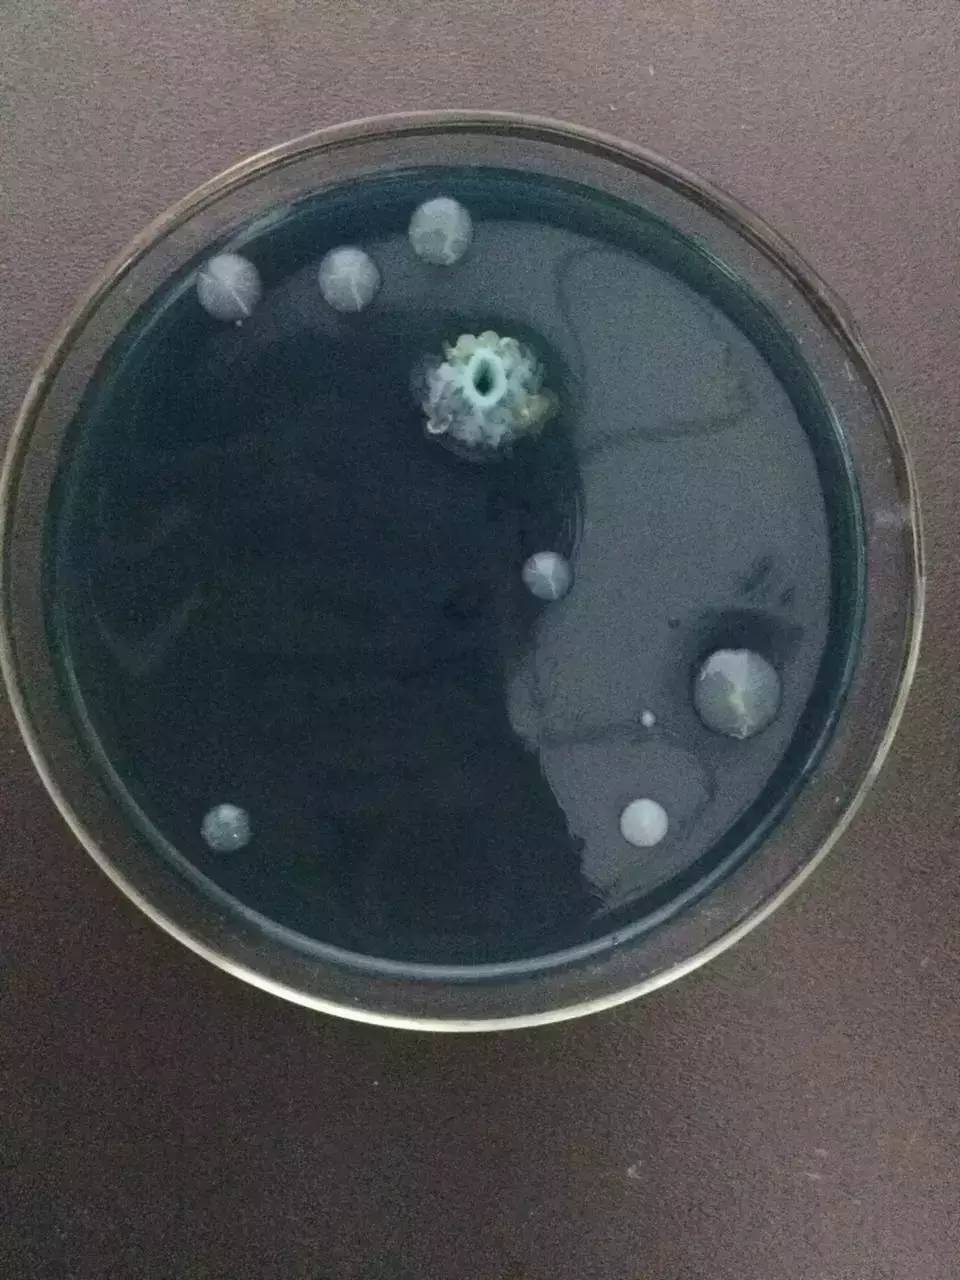
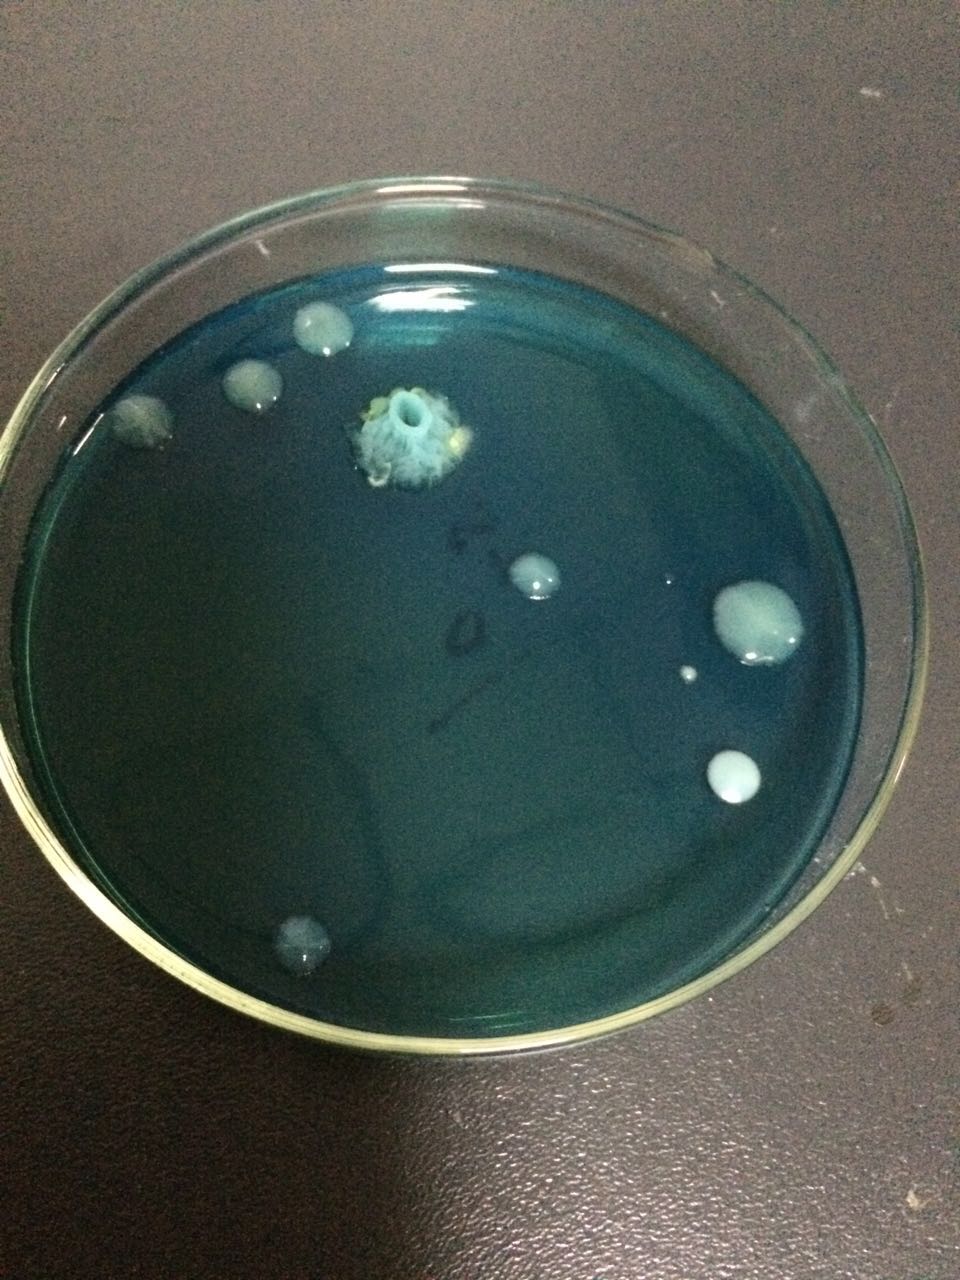

| 查看: 883 | 回复: 4 | |
Jannet西西银虫 (初入文坛)
|
[求助]
这种形状突起的菌是什么菌啊 已有1人参与
|
|
|
|
|
2楼2016-03-04 15:07:58
|
|
joshuablack新虫 (小有名气)
|
|
|
3楼2016-03-04 15:43:37
|
|
Jannet西西银虫 (初入文坛)
|
|
|
4楼2016-03-04 20:51:08
|
|
joshuablack新虫 (小有名气)
|
|
|
5楼2016-03-05 10:55:09
|
|

回复此楼